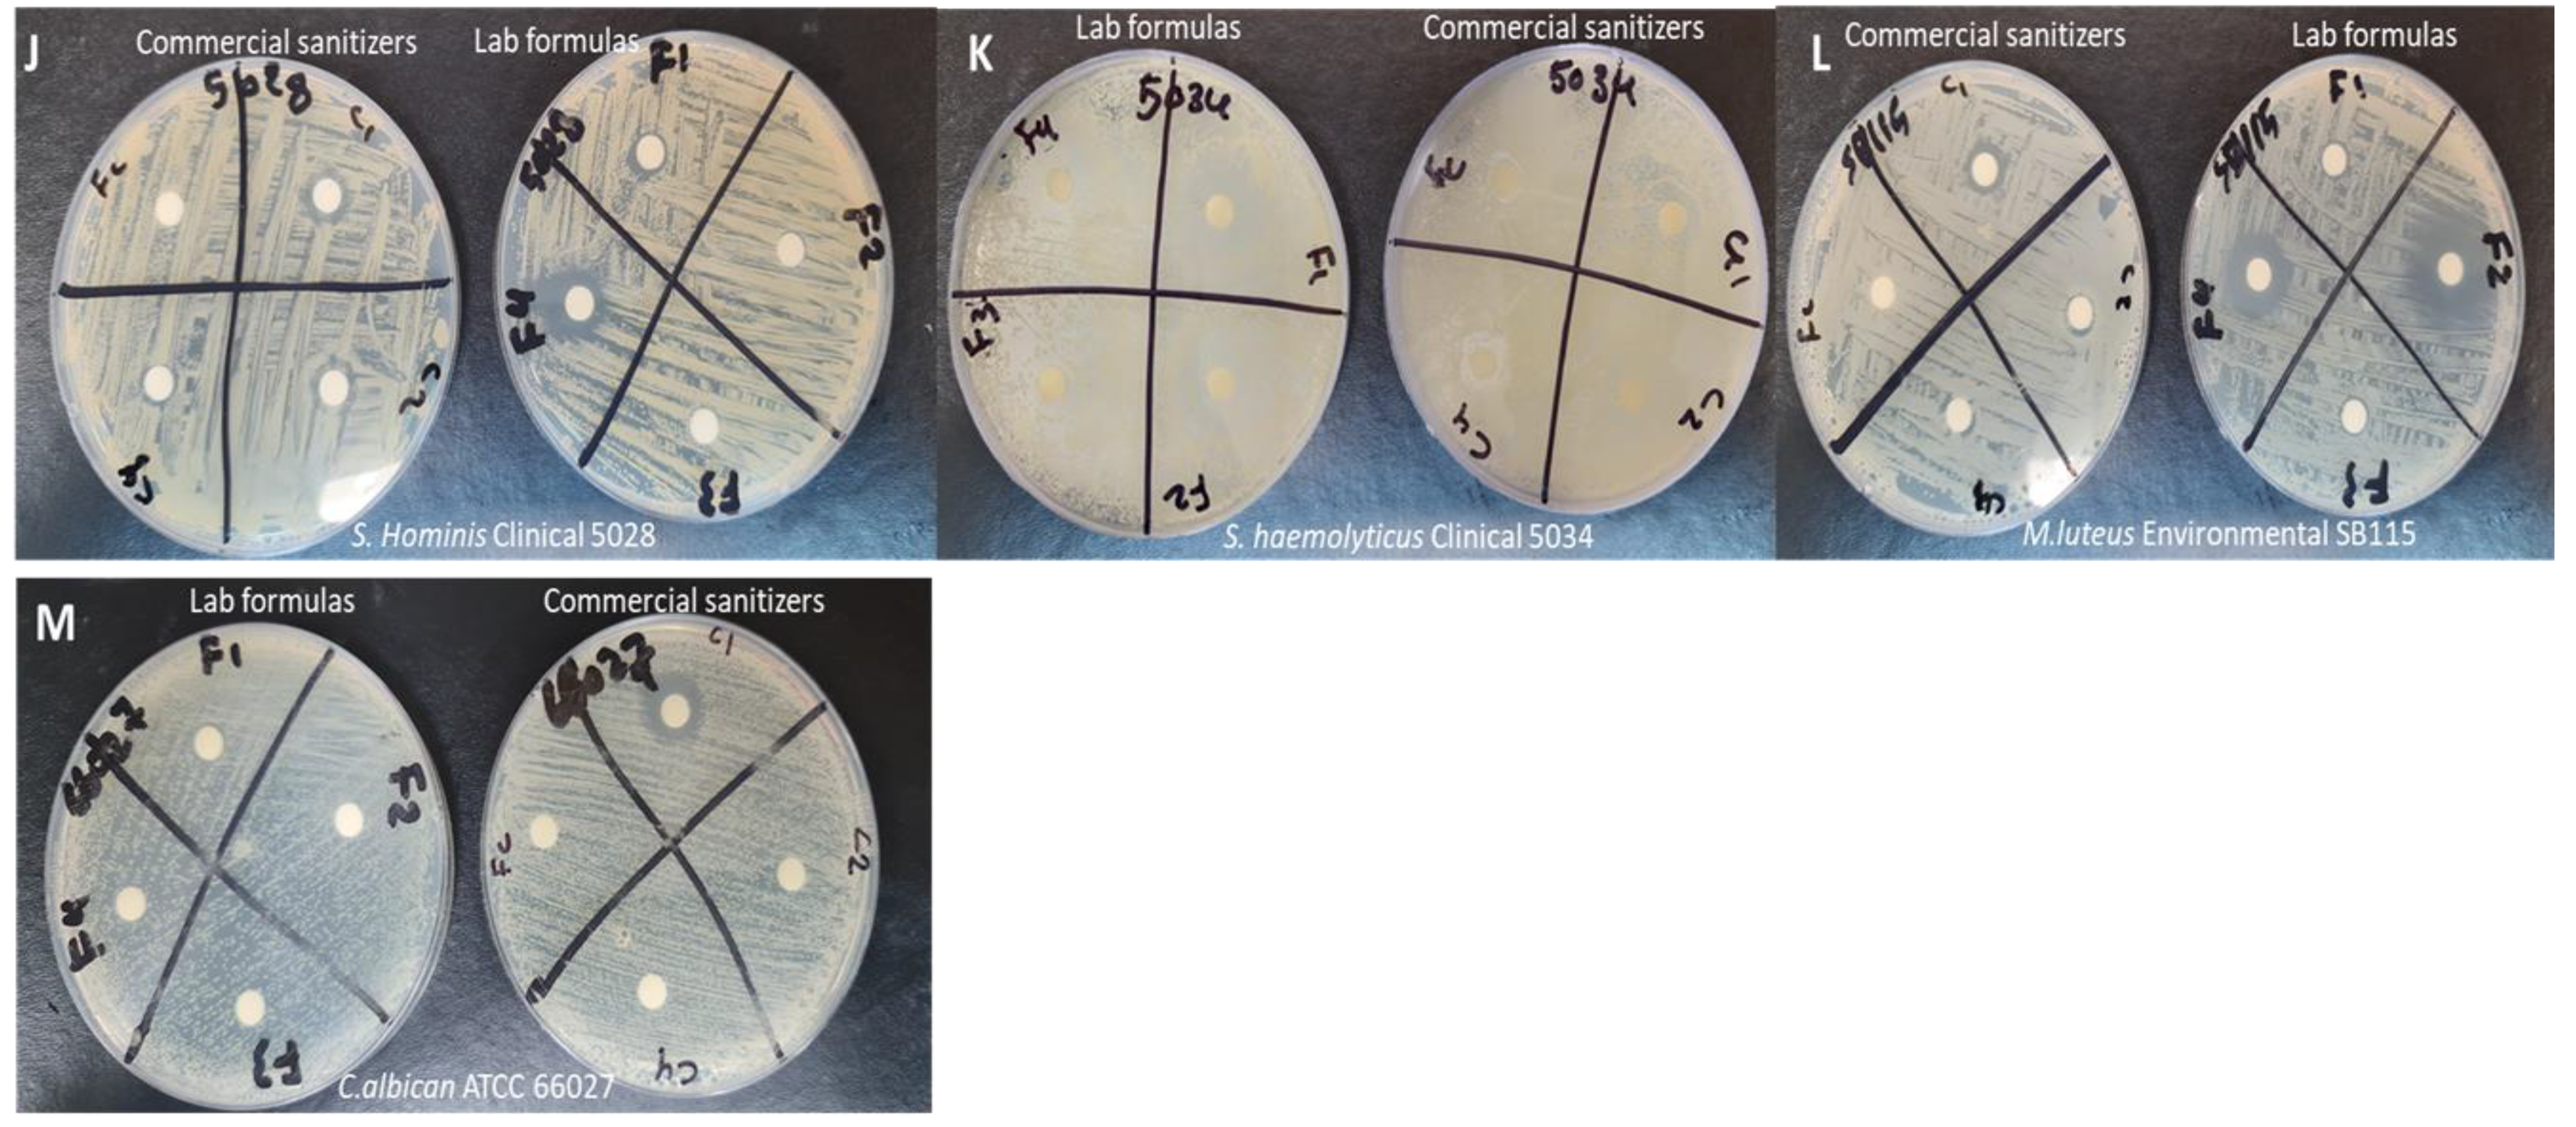

Formulation and Evaluation of Alcohol-Free Hand Sanitizer Gels to Prevent the Spread of Infections during Pandemics
Abstract
1. Introduction
2. Materials and Methods
2.1. Materials
2.2. Methods
2.2.1. Preparation of Hand Sanitizer Gels
2.2.2. Physiochemical Characterization and Evaluation of Hand Sanitizer Gels
Organoleptic Test
pH Evaluation
Viscosity (Rheological Properties)
Gel Spreadability
2.2.3. Microbial Suspension Preparation
2.2.4. Antimicrobial Zone of Inhibition Test
2.2.5. Skin Irritation Study (Acceptability Test)
2.2.6. Statistical Analysis
3. Results and Discussion
3.1. Characterization and Evaluation of Hand Sanitizer Gels
3.1.1. Organoleptic Test
3.1.2. pH Evaluation
3.1.3. Viscosity (Rheological Properties)
3.1.4. Gel Spreadability
3.2. Antimicrobial Zone of Inhibition Assay
3.3. Acceptability Test (Skin Irritation Study)
4. Conclusions
Author Contributions
Funding
Institutional Review Board Statement
Informed Consent Statement
Data Availability Statement
Conflicts of Interest
Appendix A

References
- Pittet, D.; Allegranzi, B.; Boyce, J. The World Health Organization Guidelines on Hand Hygiene in Health Care and Their Consensus Recommendations. Infect. Control Hosp. Epidemiol. 2009, 30, 611–622. [Google Scholar] [CrossRef]
- Zhou, P.; Liu, Z.; Chen, Y.; Xiao, Y.; Huang, X.; Fan, X.G. Bacterial and fungal infections in COVID-19 patients: A matter of concern. Infect. Control Hosp. Epidemiol. 2020, 41, 1124–1125. [Google Scholar] [CrossRef] [PubMed]
- Manohar, P.; Loh, B.; Nachimuthu, R.; Hua, X.; Welburn, S.C.; Leptihn, S. Secondary Bacterial Infections in Patients with Viral Pneumonia. Front. Med. 2020, 7, 420. [Google Scholar] [CrossRef] [PubMed]
- Contou, D.; Claudinon, A.; Pajot, O.; Micaëlo, M.; Longuet Flandre, P.; Dubert, M.; Cally, R.; Logre, E.; Fraissé, M.; Mentec, H.; et al. Bacterial and viral co-infections in patients with severe SARS-CoV-2 pneumonia admitted to a French ICU. Ann. Intensive Care 2020, 10, 119. [Google Scholar] [CrossRef] [PubMed]
- Golin, A.P.; Choi, D.; Ghahary, A. Hand sanitizers: A review of ingredients, mechanisms of action, modes of delivery, and efficacy against coronaviruses. Am. J. Infect. Control 2020, 48, 1062–1067. [Google Scholar] [CrossRef] [PubMed]
- WHO Guidelines Approved by the Guidelines Review Committee. In WHO Guidelines on Hand Hygiene in Health Care: First Global Patient Safety Challenge Clean Care Is Safer Care; World Health Organization Copyright © 2009; World Health Organization: Geneva, Switzerland, 2009.
- Barrett, M.J.; Babl, F.E. Alcohol-based hand sanitiser: A potentially fatal toy. Med. J. Aust. 2015, 203, 43–44. [Google Scholar] [CrossRef][Green Version]
- Mahmood, A.; Eqan, M.; Pervez, S.; Alghamdi, H.A.; Tabinda, A.B.; Yasar, A.; Brindhadevi, K.; Pugazhendhi, A. COVID-19 and frequent use of hand sanitizers; human health and environmental hazards by exposure pathways. Sci. Total Environ. 2020, 742, 140561. [Google Scholar] [CrossRef]
- Saoo, K.; Miki, H.; Ohmori, M.; Winters, W.D. Antiviral Activity of Aloe Extracts against Cytomegalovirus. Phytother. Res. 1996, 10, 348–350. [Google Scholar] [CrossRef]
- Shapiro, S.S.; Saliou, C. Role of vitamins in skin care. Nutrition 2001, 17, 839–844. [Google Scholar] [CrossRef]
- Jing, J.L.; Pei Yi, T.; Bose, R.J.; McCarthy, J.R.; Tharmalingam, N.; Madheswaran, T. Hand Sanitizers: A Review on Formulation Aspects, Adverse Effects, and Regulations. Int. J. Environ. Res. Public Health 2020, 17, 3326. [Google Scholar] [CrossRef]
- Matan, N.; Rimkeeree, H.; Mawson, A.J.; Chompreeda, P.; Haruthaithanasan, V.; Parker, M. Antimicrobial activity of cinnamon and clove oils under modified atmosphere conditions. Int. J. Food Microbiol. 2006, 107, 180–185. [Google Scholar] [CrossRef]
- Javed, S.; Atta-ur, R. Chapter 9—Aloe Vera Gel in Food, Health Products, and Cosmetics Industry. In Studies in Natural Products Chemistry; Atta-ur, R., Ed.; Elsevier: Amsterdam, The Netherlands, 2014; Volume 41, pp. 261–285. [Google Scholar]
- Sarkic, A.; Stappen, I. Essential Oils and Their Single Compounds in Cosmetics—A Critical Review. Cosmetics 2018, 5, 11. [Google Scholar] [CrossRef]
- Uter, W.; Schmidt, E.; Geier, J.; Lessmann, H.; Schnuch, A.; Frosch, P. Contact allergy to essential oils: Current patch test results (2000-2008) from the Information Network of Departments of Dermatology (IVDK). Contact Dermat. 2010, 63, 277–283. [Google Scholar] [CrossRef]
- Rutherford, T.; Nixon, R.; Tam, M.; Tate, B. Allergy to tea tree oil: Retrospective review of 41 cases with positive patch tests over 4.5 years. Australas. J. Dermatol. 2007, 48, 83–87. [Google Scholar] [CrossRef]
- Greenaway, R.E.; Ormandy, K.; Fellows, C.; Hollowood, T. Impact of hand sanitizer format (gel/foam/liquid) and dose amount on its sensory properties and acceptability for improving hand hygiene compliance. J. Hosp. Infect. 2018, 100, 195–201. [Google Scholar] [CrossRef]
- Al-Suwayeh, S.A.; Taha, E.I.; Al-Qahtani, F.M.; Ahmed, M.O.; Badran, M.M. Evaluation of Skin Permeation and Analgesic Activity Effects of Carbopol Lornoxicam Topical Gels Containing Penetration Enhancer. Sci. World J. 2014, 2014, 127495. [Google Scholar] [CrossRef]
- Aburayan, W.S.; Booq, R.Y.; BinSaleh, N.S.; Alfassam, H.A.; Bakr, A.A.; Bukhary, H.A.; Alyamani, E.J.; Tawfik, E.A. The Delivery of the Novel Drug ‘Halicin’ Using Electrospun Fibers for the Treatment of Pressure Ulcer against Pathogenic Bacteria. Pharmaceutics 2020, 12, 1189. [Google Scholar] [CrossRef] [PubMed]
- Surini, S.; Amirtha, N.I.; Lestari, D.C. Formulation and effectiveness of a hand sanitizer gel produced using salam bark extract. Int. J. Appl. Pharm. 2018, 10, 216–220. [Google Scholar] [CrossRef][Green Version]
- Rahmasari, D.; Hendradi, E.; Chasanah, U. Formulation and evaluation of hand sanitizer gel containing infused of binahong leaf (Anredera cordifolia) as antibacterial preparation. Farmasains J. Farm. dan Ilmu Kesehat. 2020, 5, 23–30. [Google Scholar] [CrossRef]
- Lambers, H.; Piessens, S.; Bloem, A.; Pronk, H.; Finkel, P. Natural skin surface pH is on average below 5, which is beneficial for its resident flora. Int. J. Cosmet. Sci. 2006, 28, 359–370. [Google Scholar] [CrossRef]
- Ali, S.M.; Yosipovitch, G. Skin pH: From basic science to basic skin care. Acta Derm. Venereol. 2013, 93, 261–267. [Google Scholar] [CrossRef]
- Rippke, F.; Schreiner, V.; Schwanitz, H.J. The acidic milieu of the horny layer: New findings on the physiology and pathophysiology of skin pH. Am. J. Clin. Dermatol. 2002, 3, 261–272. [Google Scholar] [CrossRef] [PubMed]
- Parra, J.L.; Paye, M. EEMCO guidance for the in vivo assessment of skin surface pH. Skin Pharmacol. Appl. Skin Physiol. 2003, 16, 188–202. [Google Scholar] [CrossRef] [PubMed]
- Schittek, B.; Hipfel, R.; Sauer, B.; Bauer, J.; Kalbacher, H.; Stevanovic, S.; Schirle, M.; Schroeder, K.; Blin, N.; Meier, F.; et al. Dermcidin: A novel human antibiotic peptide secreted by sweat glands. Nat. Immunol. 2001, 2, 1133–1137. [Google Scholar] [CrossRef] [PubMed]
- Korting, H.C.; Hübner, K.; Greiner, K.; Hamm, G.; Braun-Falco, O. Differences in the skin surface pH and bacterial microflora due to the long-term application of synthetic detergent preparations of pH 5.5 and pH 7.0. Results of a crossover trial in healthy volunteers. Acta Derm. Venereol. 1990, 70, 429–431. [Google Scholar]
- Quiñones, D.; Ghaly, E.S. Formulation and characterization of nystatin gel. Puerto Rico Health Sci. J. 2008, 27, 61–67. [Google Scholar]
- Oghenemaro, E.F.; Johnson, J.; Itohan, I.M.; Richard, S.O.; Michael, O. Antimicrobial activity of aloe vera gel and honey against bacteria isolates from wound aspirates. Int. J. Pharm. Sci. Res. 2018, 9, 4890–4893. [Google Scholar] [CrossRef]
- Pawar, V.; Bagatharia, S.; Thaker, V. Antibacterial activity of Aloe vera leaf gel extracts against Staphylococcus aureus. Indian J. Microbiol. 2005, 45, 227. [Google Scholar]
- Dal’Belo, S.E.; Rigo Gaspar, L.; Berardo Gonçalves Maia Campos, P.M. Moisturizing effect of cosmetic formulations containing Aloe vera extract in different concentrations assessed by skin bioengineering techniques. Skin Res. Technol. 2006, 12, 241–246. [Google Scholar] [CrossRef]
- Jain, V.M.; Karibasappa, G.N.; Dodamani, A.S.; Prashanth, V.K.; Mali, G.V. Comparative assessment of antimicrobial efficacy of different hand sanitizers: An in vitro study. Dent. Res. J. 2016, 13, 424–431. [Google Scholar] [CrossRef]
- Chee, H.Y.; Lee, M.H. Antifungal activity of clove essential oil and its volatile vapour against dermatophytic fungi. Mycobiology 2007, 35, 241–243. [Google Scholar] [CrossRef] [PubMed][Green Version]
- Nzeako, B.C.; Al-Kharousi, Z.S.; Al-Mahrooqui, Z. Antimicrobial activities of clove and thyme extracts. Sultan Qaboos Univ. Med. J. 2006, 6, 33–39. [Google Scholar] [PubMed]

| Formulation Number | Essential Oils | Aloe Vera | Glycerin | Vitamin E | Distilled Water |
|---|---|---|---|---|---|
| F1 | 2.5% (v/v)—Clove oil | 90% (v/v) | 5% (v/v) | 0.05% (v/v) | 2.45% (v/v) |
| F2 | 1.25% (v/v)—Clove oil | 3.70% (v/v) | |||
| F3 | 2.5% (v/v)—Lavender oil | 2.45% (v/v) | |||
| F4 | 2.5% (v/v)—Tea tree oil | 2.45% (v/v) | |||
| Control | None | 4.95% (v/v) |
| Formulation | pH |
|---|---|
| F1 | 3.9 ± 0.0 |
| F2 | 3.9 ± 0.0 |
| F3 | 3.9 ± 0.1 |
| F4 | 3.9 ± 0.1 |
| Control | 3.9 ± 0.0 |
| Formulation | Viscosity (cP) |
|---|---|
| F1 | 1.1 ± 0.10 |
| F2 | 1.0 ± 0.02 |
| F3 | 1.0 ± 0.03 |
| F4 | 1.0 ± 0.02 |
| Control | 0.9 ± 0.01 |
| Water | 0.9 ± 0 |
| Ethanol | 0.9 ± 0 |
| Formulation | Spreadability (%) |
|---|---|
| F1 | 558 ± 3 |
| F2 | 638 ± 3 |
| F3 | 622 ± 6 |
| F4 | 622 ± 3 |
| Formulation | A. baumannii BAA 747 (mm) | E. coli ATCC 25,922 (mm) | E. coli 1060 (mm) | K. pneumoniae BAA 1705 (mm) | P. aeruginosa BAA 1744 (mm) | P. aeruginosa ATCC 27,853 (mm) |
|---|---|---|---|---|---|---|
| F1 | 9 ± 1 | 8 ± 1 | 8 ± 1 | 9 ± 0 | 9 ± 0 | 9 ± 2 |
| F2 | 9 ± 1 | 7 ± 1 | 7 ± 0 | 8 ± 0 | 8 ± 0 | 9 ± 1 |
| F3 | 8 ± 0 | 0 | 8 ± 1 | 8 ± 0 | 8 ± 0 | 0 |
| F4 | 18 ± 2 | 7 ± 1 | 9 ± 0 | 12 ± 0 | 12 ± 0 | 10 ± 2 |
| C1 | 12 ± 0 | 13 ± 1 | 9 ± 0 | 10 ± 1 | 10 ± 1 | 10 ± 2 |
| C2 | 14 ± 2 | 6 ± 0 | 10 ± 0 | 9 ± 1 | 9 ± 1 | 10 ± 1 |
| C3 | 10 ± 1 | 6 ± 0 | 8 ± 1 | 10 ± 1 | 10 ± 1 | 9 ± 1 |
| Control | 0 | 0 | 0 | 0 | 0 | 0 |
| Formulation | S. aureus ATCC 29,213 (mm) | S. aureus BAA 977 (mm) | S. epidermidis 5029 (mm) | S. hominis 5028 (mm) | S. haemolyticus ATCC 5034 (mm) | M. luteus SB115 (mm) |
|---|---|---|---|---|---|---|
| F1 | 13 ± 2 | 9 ± 2 | 9 ± 0 | 9 ± 0 | 13 ± 3 | 9 ± 1 |
| F2 | 10 ± 2 | 8 ± 1 | 8 ± 1 | 7 ± 0 | 9 ± 0 | 14 ± 5 |
| F3 | 8 ± 1 | 9 ± 0 | 8 ± 0 | 7 ± 0 | 7 ± 1 | 9 ± 0 |
| F4 | 14 ± 1 | 17 ± 1 | 20 ± 1 | 13 ± 1 | 12 ± 2 | 17 ± 2 |
| C1 | 11 ± 5 | 11 ± 2 | 9 ± 1 | 10 ± 0 | 12 ± 0 | 11 ± 1 |
| C2 | 8 ± 1 | 9 ± 0 | 9 ± 0 | 9 ± 1 | 6 ± 0 | 9 ± 1 |
| C3 | 7 ± 1 | 8 ± 0 | 8 ± 0 | 8 ± 1 | 7 ± 1 | 8 ± 0 |
| Control | 0 | 0 | 8 ± 1 | 0 | 0 | 0 |
| Formulation | C. albicans ATCC 66,027 (mm) |
|---|---|
| F1 | 7 ± 1 |
| F2 | 7 ± 1 |
| F3 | 0.00 |
| F4 | 0.00 |
| C1 | 13 ± 2 |
| C2 | 0.00 |
| C3 | 0.00 |
| Control | 0.00 |
Publisher’s Note: MDPI stays neutral with regard to jurisdictional claims in published maps and institutional affiliations. |
© 2021 by the authors. Licensee MDPI, Basel, Switzerland. This article is an open access article distributed under the terms and conditions of the Creative Commons Attribution (CC BY) license (https://creativecommons.org/licenses/by/4.0/).
Share and Cite
Booq, R.Y.; Alshehri, A.A.; Almughem, F.A.; Zaidan, N.M.; Aburayan, W.S.; Bakr, A.A.; Kabli, S.H.; Alshaya, H.A.; Alsuabeyl, M.S.; Alyamani, E.J.; et al. Formulation and Evaluation of Alcohol-Free Hand Sanitizer Gels to Prevent the Spread of Infections during Pandemics. Int. J. Environ. Res. Public Health 2021, 18, 6252. https://doi.org/10.3390/ijerph18126252
Booq RY, Alshehri AA, Almughem FA, Zaidan NM, Aburayan WS, Bakr AA, Kabli SH, Alshaya HA, Alsuabeyl MS, Alyamani EJ, et al. Formulation and Evaluation of Alcohol-Free Hand Sanitizer Gels to Prevent the Spread of Infections during Pandemics. International Journal of Environmental Research and Public Health. 2021; 18(12):6252. https://doi.org/10.3390/ijerph18126252
Chicago/Turabian StyleBooq, Rayan Y., Abdullah A. Alshehri, Fahad A. Almughem, Nada M. Zaidan, Walaa S. Aburayan, Abrar A. Bakr, Sara H. Kabli, Hassa A. Alshaya, Mohammed S. Alsuabeyl, Essam J. Alyamani, and et al. 2021. "Formulation and Evaluation of Alcohol-Free Hand Sanitizer Gels to Prevent the Spread of Infections during Pandemics" International Journal of Environmental Research and Public Health 18, no. 12: 6252. https://doi.org/10.3390/ijerph18126252
APA StyleBooq, R. Y., Alshehri, A. A., Almughem, F. A., Zaidan, N. M., Aburayan, W. S., Bakr, A. A., Kabli, S. H., Alshaya, H. A., Alsuabeyl, M. S., Alyamani, E. J., & Tawfik, E. A. (2021). Formulation and Evaluation of Alcohol-Free Hand Sanitizer Gels to Prevent the Spread of Infections during Pandemics. International Journal of Environmental Research and Public Health, 18(12), 6252. https://doi.org/10.3390/ijerph18126252

